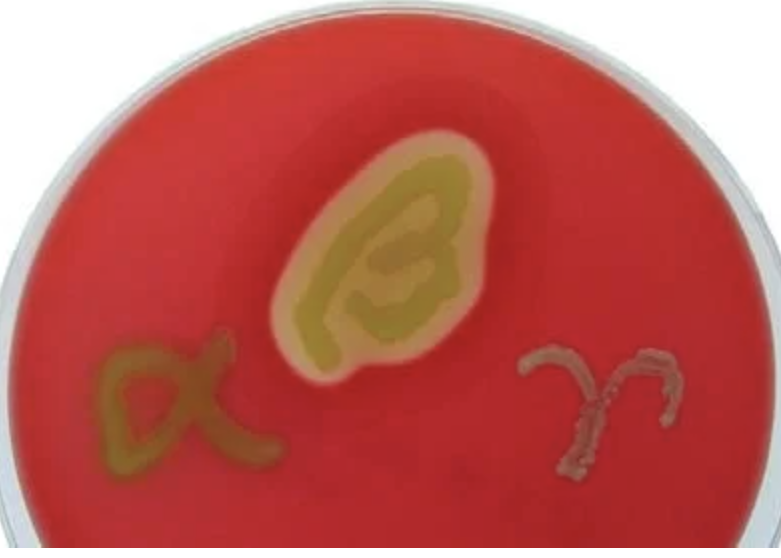
<p>What test is this?</p>
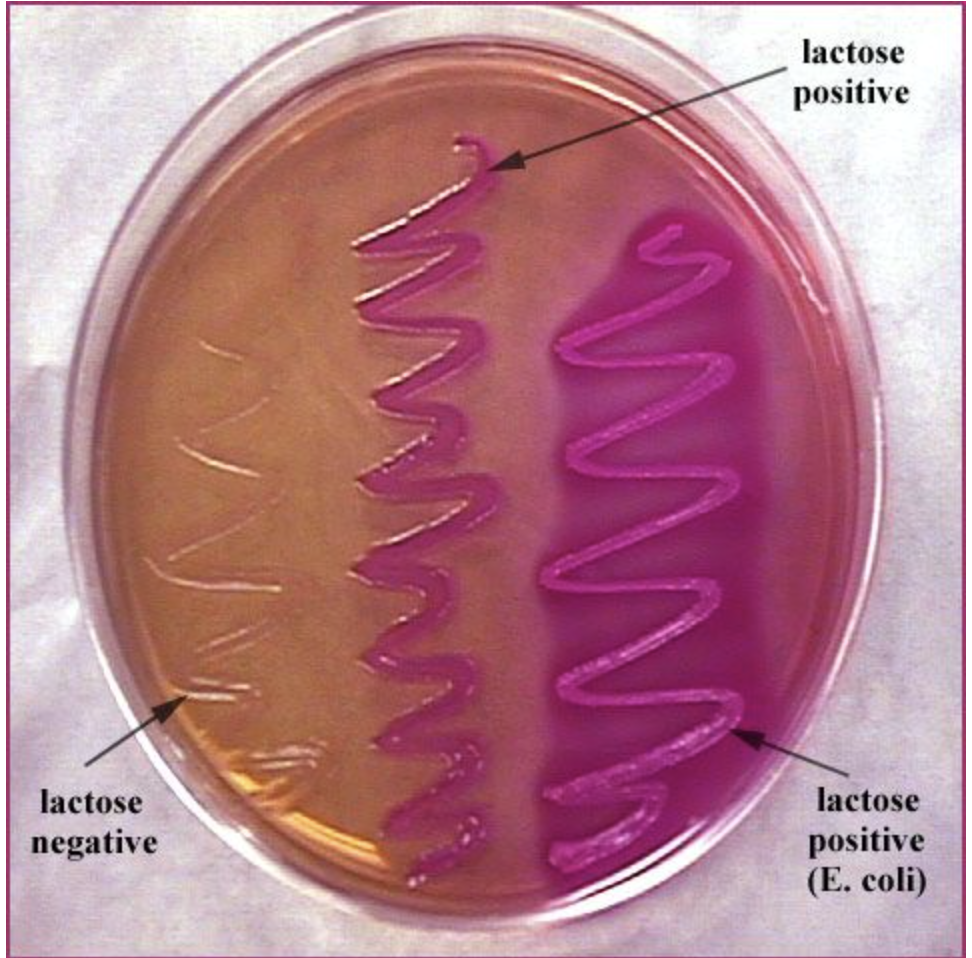
<p>What test is this?</p>
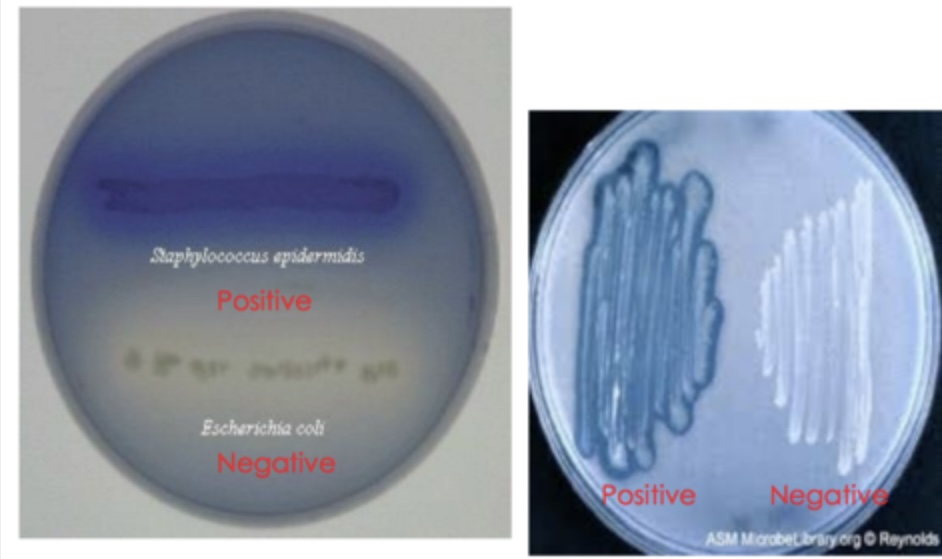
<p>What test is this?</p>
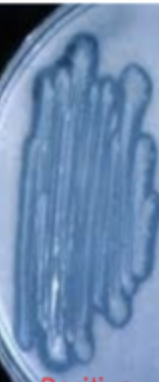
<p>Is this a negative or positive Lipid hydrolysis (Sprit blue agar) test?</p>
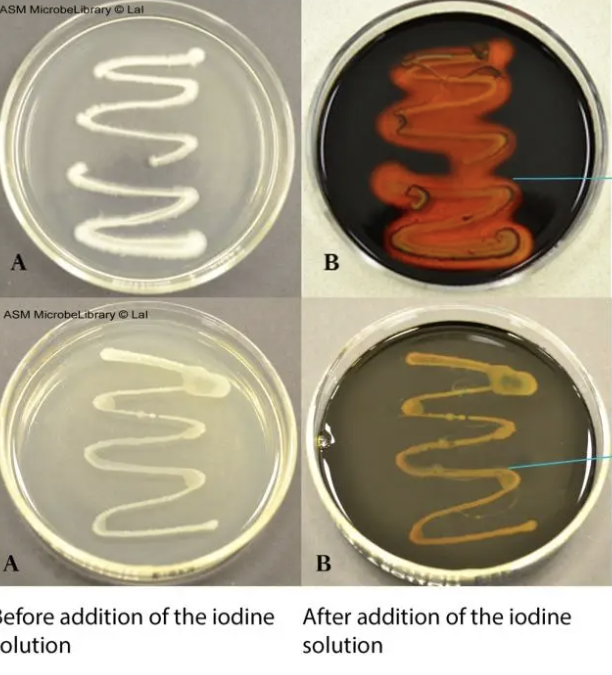
<p>What test is this?</p>
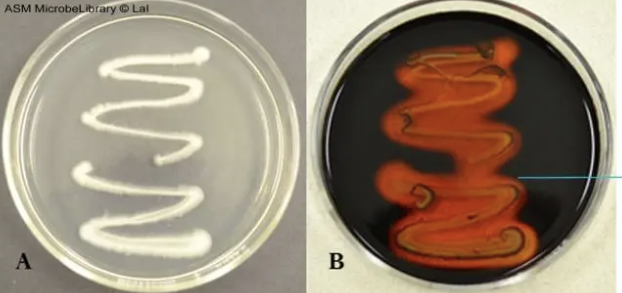
<p>Is this a positive or negative Starch hydrolysis (Starch agar)?</p>
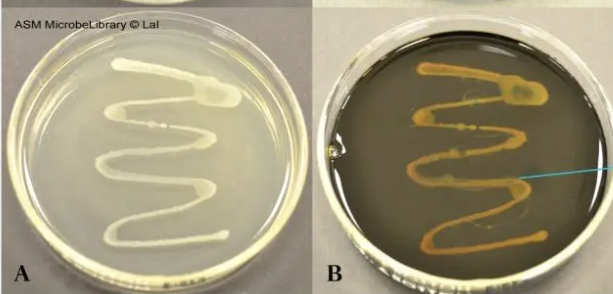
<p>Is this a positive or negative Starch hydrolysis (Starch agar)?</p>
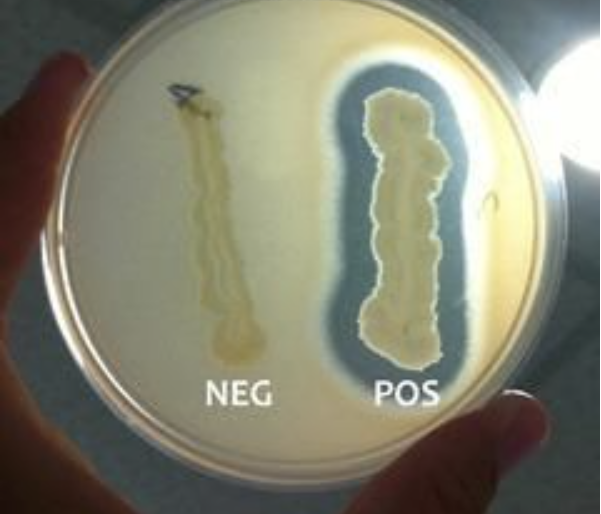
<p>What test is this?</p>

1/46
Looks like no tags are added yet.
Name | Mastery | Learn | Test | Matching | Spaced | Call with Kai |
|---|
No analytics yet
Send a link to your students to track their progress
What test is this?
Blood agar
What test is this?
MacConkey agar

What test is this?
Catalase test

Is this a positive or negative catalase test?
Positive- Catalase test

What test is this?
Oxidase test

Is this a positive or negative catalase test?
Negative -Catalase test

Is this a positive or negative oxidase test?
Posiitive-Oxidase test

Is this a positive or negative oxidase test?
Negative-Oxidase test

What test is this?
Indole test

Is this a positive or negative Indole test?
Positive-Indole test

Is this a positive or negative Indole test?
Negative-Indole test

What test is this?
Carbohydrate fermentation

Is this a positive or negative Carbohydrate fermentation test?
Negative-Carbohydrate fermentation

Is this a positive or negative Carbohydrate fermentation test?
Positive-Carbohydrate fermentation

What kind of test is this?
Motility agar

Is this a positive or negative motility agar test?
Negative-Motility agar

Is this a positive or negative motility agar test?
Positive-Motility agar

What kind of test is this?
Simmon’s citrate agar

Is this a positive or negative Simmon’s citrate agar?
Negative-Simmon’s citrate agar

Is this a positive or negative Simmon’s citrate agar?
Positive-Simmon’s citrate agar
What test is this?
Lipid hydrolysis (Sprit blue agar)

Is this a negative or positive Lipid hydrolysis (Sprit blue agar) test?
Positive-Lipid hydrolysis (Sprit blue agar)

Is this a negative or positive Lipid hydrolysis (Sprit blue agar) test?
Negative-Lipid hydrolysis (Sprit blue agar)
Is this a negative or positive Lipid hydrolysis (Sprit blue agar) test?
Positive-Lipid hydrolysis (Sprit blue agar)

Is this a negative or positive Lipid hydrolysis (Sprit blue agar) test?
Negative-Lipid hydrolysis (Sprit blue agar)
What test is this?
Starch hydrolysis (Starch agar)
Is this a positive or negative Starch hydrolysis (Starch agar)?
Positive-Starch hydrolysis (Starch agar)
Is this a positive or negative Starch hydrolysis (Starch agar)?
Negativie-Starch hydrolysis (Starch agar)
What test is this?
Protein Hydrolysis (Skim milk agar)

Is this a positive or negative Protein Hydrolysis (Skim milk agar) test?
Negative-Protein Hydrolysis (Skim milk agar)

Is this a positive or negative Protein Hydrolysis (Skim milk agar) test?
Positive-Protein Hydrolysis (Skim milk agar)

Is this a positive or negative VP test?
Positive-Voges-Proskauer

Is this a positive or negative VP test?
Negative-Voges-Proskauer

Is this a positive or negative VP test?
Positive-Voges-Proskauer

Is this a positive or negative VP test?
Negative-Voges-Proskauer

What test is this?
Voges-Proskauer

Is this a positive or negative Urease test?
Negative-Urease test

Is this a positive or negative Urease test?
Positive-Urease test

What test is this?
Urease test

What test is this?
Kliger’s Iron Agar

What test is this?
Nitrate reduction test

Is this a positive or negative Kliger’s Iron Agar test?
Negative-Kliger’s Iron Agar

Is this a positive or negative Kliger’s Iron Agar test?
Positive-Kliger’s Iron Agar

If the nitrate broth turns red after nitrate I and nitrate II are added, this color indicates a…
Positive-Nitrate reduction test (2)

If the tube turns red after the addition of Zn, this indicates a…
Negative-Nitrate reduction test

If there is no color change in the tube after the addition of nitrate I and nitrate II, the result is…
Uncertain-Nitrate reduction test

f the tube is colorless after the addition of nitrate I and nitrate II and then Zn this indicates a…
Positive-Nitrate reduction test (3)